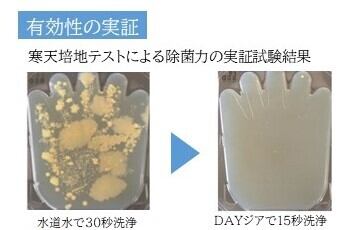

1/10
次亜塩素酸水「DAYジア」30ppm20Lコックなし
¥4,999
International shipping available
商品名:除菌消臭 微酸性次亜塩素酸水【DAYジア】
成 分:次亜塩素酸水 有効塩素濃度:30ppm(製造時)
生成方法:希塩酸・塩化ナトリウムを電解質として電気分解により生成
内容量:350ml 5本
液性:微酸性(㏗5.0~6.5) 日本製
消費期限:記載の製造年月日より2か月以内(紫外線に当たると効果が減少します。別容器に移し替える際は遮光性のボトルを使用し冷暗所での保管をお願いします。)
.
使用上の注意
1.空間および環境表面の除菌・消臭以外に使用しないでください。
2.高温・直射日光を避け幼児の手の届かない、冷暗所に保管してください。
3.飲用ではありません。目に入ったらすぐに洗い流してください。
4.塩素アレルギーの方は、使用をお控えください。
5.使用中、気分が悪くなった場合は使用を中止し、換気してください。良くならない場合は医師に相談してください。
6.他の薬品・洗剤等と混合しないでください。
7.金属部分に使用する場合、さび防止のため使用後は拭いてください。
8.次亜塩素酸水対応の加湿器を必ず使用してください。
9.全てのウイルス、菌を除去するものではありません。使用環境により効果が異なる場合がございます。
配送について
北海道および沖縄へは航空搭載不可の商品になるため船便での配送になり、1週間から10日ほどお時間をいただきます。
最近チェックした商品
その他の商品